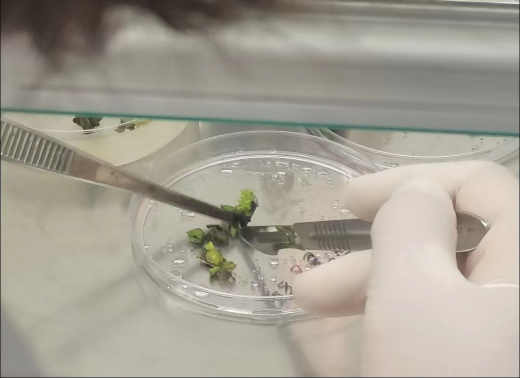

10月17日-11月18日,農學1201班開展了生産實習,35名同學分别前往了江蘇盱眙天隆種業有限公司、江蘇高科種業科技有限公司、江蘇金地種業科技有限公司、江蘇天豐種業科技有限公司、江蘇省農科院和淮安市農業科學研究院6家實習單位進行為期五周的生産實習。
在江蘇省農科院、淮安市農科院和種業公司,同學們都進行了水稻的收獲、測查與室内考種,理解作物的産量構成因素,水稻每穗粒數、空癟粒、千粒重如何調查;大豆的單株結莢數、每莢粒數、百粒重;玉米種類的辨别、玉米脫粒、高産種子的選擇以及玉米親本的選擇等等。本學期同學們開始真正接觸專業課程《作物栽培學》和《作物育種學》,實踐與理論的有機融合,方便同學們能更好的理解和掌握書本上的知識。





10月底正值小麥的适播期,淮安市農科院的小麥品種參加了國家區域性試驗,小麥材料需要進行選種、播種。同學們在實習過程中深刻掌握了小麥選種的各種技巧:可以依據地力水平、播期和播量綜合選擇,也可以根據小麥高産、穩産的必備性狀選擇;知曉了小麥的播種時間,播種量與播種方法,播種量過大或過小的缺點;了解了播種量與土壤墒情和土壤肥力有關;測試了小麥條播機的效率,為其接下來的改良提供了自己的寶貴意見。同學們還了解了播種完成後如何留種及其保存條件。



在實習中, 經過了幾個實驗,同學們也能夠熟練使用 PCR 儀器對目的 DNA 片段的擴增,點樣到疑膠上通過電泳檢測及凝膠紫外透射分析觀察,篩選出所需的目标 DNA 片段;能夠有效避免提取DNA時的一些問題,不取老葉,其含有較多的多糖和酚類物質等雜質,加大了純化的難度;提取葉片DNA最好将葉片剪碎,防止磨得不充分;抽提時不要有大力振動,操作也要仔細,避免DNA斷裂;PCR産物的電泳檢測時間:一般是48h以内,最好當日電泳,大于48h後帶型不規則甚至消失。

本次生産實習讓每位同學都受益匪淺,通過實地動手操作,對課堂上已學理論知識有了進一步的了解掌握,對未學的專業知識有了提前的了解;顯著提高了動手操作能力,有效促進了理論與實踐的緊密結合。同時,生産校外實習老師們以多年總結的經驗給毎一位參與生産實習學生帶來異彩豐呈的體驗,他們的人格魅力和科研精神使毎位學生深深敬佩,增強了學生對所學專業的興趣,培養了追求卓越、嚴謹細緻的科研作風和吃苦耐勞的精神。同學們在實習單位的表現也得到了認可與贊揚。

在今天,農業生産正在全面實現現代化,機械農業、數字農業、智慧農業,正在取代傳統的農業勞動。我們需要加強涉農高校耕讀教育,着重培養複合型農業人才,推進中國農業現代化。